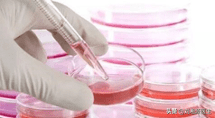
封闭抗体弱阳性需要治疗吗 封闭抗体弱阳性怎么办

文章插图
图2 酶联免疫测定法检测封闭抗体
7. 如何用混合淋巴细胞培养及抑制试验检测封闭抗体?
答:丈夫的淋巴细胞(激活细胞)与患者的淋巴细胞(反应细胞),检测患者淋巴细胞相对刺激率(母细胞转化率,即混合淋巴细胞反应),然后再加患者的血清(有否有封闭抗体)进行培养,计算患者淋巴细胞反应相对抑制率,检测患者血清中抗滋养细胞及淋巴细胞交叉反应抗原(TLX)抗体 。见图3 。
文章插图
图3 混合淋巴细胞培养及抑制试验检测封闭抗体
8. 如何用流式细胞分析检测封闭抗体?
答:用流式细胞分析产妇血清中封闭抗体对配偶外周血T淋巴细胞CD3、CD4、CD8的封闭效率(已有妊娠或流产史的产妇应该有封闭抗体存在) 。其特点是检测多个CD抗原,准确率较高(检验结果示例,见图4和图5) 。

文章插图
图4 流式细胞仪分析封闭抗体

文章插图
图5 封闭抗体检测结果解读
9.封闭抗体是怎样保护胚胎的?
答:正常情况下,封闭抗体在孕初期就开始产生,至孕3个月达高峰,之后逐步降低,到分娩时又开始增高,并随着妊娠次数增加而增加(无妊娠史母亲的封闭抗体应是阴性) ,存在于胎盘血、脐血和外周血中 。
(1)封闭抗体与滋养细胞表面特异性抗原结合,通过阻断母儿之间免疫识别和免疫反应,从而封闭母体淋巴细胞对滋养细胞的细胞毒作用;
(2)可直接针对T或B淋巴细胞表面特异性抗原受体(BCR/TCR),阻断有害免疫应答;
(3)通过阻断细胞毒细胞(CTL)和自然杀伤细胞(NK)等产生细胞毒性作用 。
10.检测封闭抗体到底有何临床意义?
答:反复自然流产的发生可能与母体缺乏封闭抗体有关,流产次数越多的患者,其体内封闭抗体缺乏的可能性越大 。患者体内缺乏抗配偶CD3、CD4、CD8抗原的封闭抗体(见图6),母体对胎儿(半同种异体移植物)产生强烈的排斥反应,孕早期可导致反复自然流产,孕晚期则出现妊娠高血压疾病,胎儿宫内生长受限、甚至胎死宫内 。

文章插图
图6 封闭抗体缺乏示意图
11.封闭抗体阴性是否正常?
答:封闭抗体是在妊娠早期由胚胎父源性HLA抗原刺激母体产生的胎儿保护性抗体(IgG3),如果没有其他途径诱导产生封闭抗体,理论上非孕期应该是阴性的,怀孕后转阳 。如果没有复发性不良妊娠,也不想怀孕,不需要检查封闭抗体 。对于反复发生不良妊娠,迫切需要孕育一个正常孩子,夫妻双方经过系统检查除外其他明确会导致不良妊娠结局的风险因素时,孕前封闭抗体阴性考虑异常,需要针对性治疗(采用配偶淋巴细胞主动免疫)转阳后怀孕 。
12.主动免疫多长时间,封闭抗体可变阳性?
答:一般情况下,女方经过3~4次主动免疫治疗后就会产生封闭抗体,少数患者没有产生封闭抗体,可以补充治疗1~2次会转阳,尽可能在封闭抗体转阳后半年内怀孕 。
13.为何部分复发性不良妊娠患者封闭抗体持续阴性?
【封闭抗体弱阳性需要治疗吗 封闭抗体弱阳性怎么办】答:封闭抗体的产生与否或产生的多少,与母体免疫功能、夫妻遗传因素、主动免疫治疗操作等密切相关 。如夫妻双方HLA 相似位点超过2个,则用配偶的外周血提取的淋巴细胞做主动免疫治疗后,女性封闭抗体也很难转阳(没有效果) 。
- 抗原T区越红病情越严重吗 抗
- 封闭抗体包括哪些抗体 什么是封闭抗体缺乏
- 如何增加婴儿的抵抗能力 婴儿提高抵抗力
- 抗干旱草籽 耐旱草籽种类
- 保送法国晋级决赛?摩洛哥向国际足联抗议,2个点球都没判
- 遇到违法征地怎么办 如何对抗征地程序违法
- lol主播对抗赛2022 LOL主播对抗赛
- 蓝莓树苗抗寒吗 蓝莓树苗耐寒吗
- 抗锈病的玉米品种有哪些
- 孕妇抵抗力差吃什么可以增强抵抗力女性 孕妇抵抗力差吃什么
特别声明:本站内容均来自网友提供或互联网,仅供参考,请勿用于商业和其他非法用途。如果侵犯了您的权益请与我们联系,我们将在24小时内删除。
